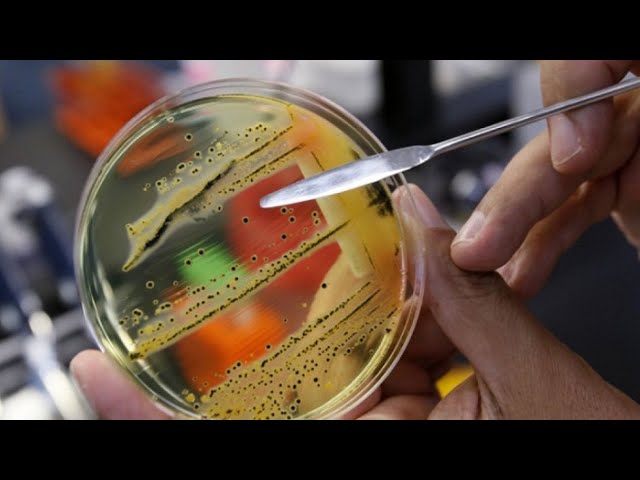
В ангарском детском саду вспышка сальмонеллеза

10 детей в больнице, еще 35 в группе риска и по осложнению инфекции.

Ярмарка «Ёлочный базар» открывается в субботу 21 декабря на городской площади.

Согласно исследованиям, люди находят под ёлкой не то, о чем мечтали. Сегодня мы спросили об этом горожанам.

Сеть фирменных магазинов Компании «Салют» и Компании «Мир Фейерверков» радует покупателей скидками, подарками и розыгрышами!

В слете юных спасателей приняли участие более шести сотен подростков со всего региона.

Строители хотели сэкономить на покрытии, мэрии пришлось искать других исполнителей.

Самые зрелищные по накалу страстей матчи 26 и 27 декабря для любителей хоккея станут новогодним подарком руководства клуба. Всё, что для этого нужно, прийти в кассу Дворца и получить бесплатный билет на матч.

Ну вот и очередная пятница и она предпоследняя в этом году!
20 декабря во всем мире отмечается Международный день солидарности. ![]()

У нас в гостях Марина Скоробогатова, руководитель сети цветочных «Fresh»Цветочная мастерская Fresh. Пообщаемся про мастер-классы и другие «изюминки» цветочных мастерских. А еще Марина прямо в студии научит нас делать новогодние хвойные композиции.

В рубрике #нуиденек Вероника Кондратьева расскажет про многодетные семьи и Абросима. Об этом писали старые газеты 20 декабря в разные годы.

В рубрике ЛюдивГолливуде Иван Шмелёв разберёт по эпизодам сагу «Звёздные войны», облачившись в джедая.